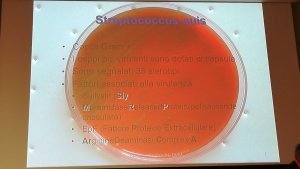

Notizie, eventi e reportage di attualità del settore suinicolo
L' Agenda di 3tre3 ti permette di essere aggiornato ogni giorno sugli eventi nazionali ed internazionali correlati con il settore suinicolo
Un riassunto settimanale delle news di 3tre3.it
Bollettino settimanale di notizie del mondo dei suini
Tutto sulla sanità suina: notizie ed articoli su malattie virali e batteriche (PRRS, PCV 2, ecc) , biosicurezza, ecc., guida alle malattie del suino, atlant
Come realizzare una necroscopia nella specie suina, passo a passo, in forma visiva e pratica
Tutte le info sulla Peste Suina Africana (PSA) su 333 e link esterni
Descrizioni delle malattie e condizioni più importanti nei suini.
Lesioni e sintomi delle principali malattie dei suini
Simulatore per diagnositcare le malattie dei suini
Calcola la quantità di prodotto da aggiungere all'acqua da bere attraverso un dosatore di flusso
Un riassunto settimanale delle news di 3tre3.it
Prezzi dei suini per paese. Produzione e commercializzazione di carni suine. Notizie di mercato e delle materie prime. Commenti sul mercato.
Ultime quotazioni del mercato suinicolo delle piazze più importanti con dati storici e grafici
Ultime quotazioni delle principali materie prime per mangimi. Grafici dei prezzi storici assieme al prezzo dei suini ed una stima del prezzo dei mangimi.
Ultime quotazioni dei principali tagli di carni suine. Storico dei prezzi in diverse valute e in formato grafico.
Quotazioni dei suini iberici nei mercati di Extremadura, Salamanca e Araporc.
Il simulatore calcola il costo di produzione ed il margine dei suini nelle condizioni italiane
Dati e tendenze delle presenze capi, produzione di carne, commercio delle carni suine, ecc
Dati della produzione e commercio mondiale delle principali materie prime
Un riassunto settimanale delle news di 3tre3.it
Informazione settimanale del prezzo del suino, delle materie prime ed inoltre un indice delle materie prime.
Articoli su nutrizione ed alimentazione di suini, materie prime, caratteristiche dei mangimi, additivi, prezzi, fabbisogni, ecc
Schede tecniche delle principali materie prime ed additivi. In più informazioni sui valori nutrizionali, produzione e commercio, ultime ricerche, ...
Ultime quotazioni delle principali materie prime per mangimi. Grafici dei prezzi storici assieme al prezzo dei suini ed una stima del prezzo dei mangimi.
Dati della produzione e commercio mondiale delle principali materie prime
Usa questo simulatore per fare la diagnosi dei problemi di resa o indice di conversione. Fai click nel diagramma di flusso o nei tasti all'interno del testo per navigare tra le varie finestre del simulatore
Un bollettino mensile di notizie sulla nutrizione suina
Articoli sulla genetica e riproduzione nei suini: selezione, genomica, inseminazione artificiale, uso di ormoni, gestazione, problemi riproduttivi...
Confronta i dati produttivi, calcola il numero di posti che hai bisogno in ogni reparto, visualizza il calendario dei lavori per settimana per ogni Banda
Calcola l'entrata delle scrofette all'inizio di un allevamento, al momento dell'ampliamento o la rimonta di una azienda in attività
Utilizza questo simulatore per sapere perchè la tua portata al parto è inferiore all'ideale. Clicca nel diagramma di flusso o nei bottoni con il testo per navigare tra le varie parti del simulatore
Un riassunto settimanale delle news di 3tre3.it
Management e gestione degli allevamenti suinicoli, organizzazione dei lavori in ogni fase produttiva, bande, ecc
Confronta i dati produttivi, calcola il numero di posti che hai bisogno in ogni reparto, visualizza il calendario dei lavori per settimana per ogni Banda
Il simulatore calcola il costo di produzione ed il margine dei suini nelle condizioni italiane
Calcola l'entrata delle scrofette all'inizio di un allevamento, al momento dell'ampliamento o la rimonta di una azienda in attività
Un riassunto settimanale delle news di 3tre3.it
Progetti di strutture ed attrezzature per allevamenti di suini: costruzioni, sistemi di ventilazione, sistemi di alimentazione, ecc. Puoi confrontare le att
Confronta i dati produttivi, calcola il numero di posti che hai bisogno in ogni reparto, visualizza il calendario dei lavori per settimana per ogni Banda
Di cosa ho bisogno nel mio allevamento? Ti facciamo vedere varie attrezzatura perche tu possa scegliere la migiore..
Un riassunto settimanale delle news di 3tre3.it
Informazioni sul settore delle carni suine: notizie, legislazione, articoli su qualità, igiene, sicurezza alimentare, e prezzi delle carni e tagli di carni.
Ultime quotazioni dei principali tagli di carni suine. Storico dei prezzi in diverse valute e in formato grafico.
Notizie sulle carni suine su 3tre3.it
Un riassunto settimanale delle news di 3tre3.it

La Società Italiana di Patologia ed Allevamento dei Suini ha organizzato il XLV Meeting Annuale presso Villa Fenaroli, Rezzato - BS, il 21 e 22 di marzo 2019. I temi principali sono stati: Peste Suina Africana e Salmonellosi.
Per commentare ti devi registrare su 3tre3 ed essere connesso.
Bollettino settimanale di notizie del mondo dei suini
Fai il log in e spunta la lista


Benvenuto su 3tre3
Condividi, partecipa, posta e fai parte del maggior social network dei suini
Siamo già 201497Utenti
RegistratiEri già un membro?
